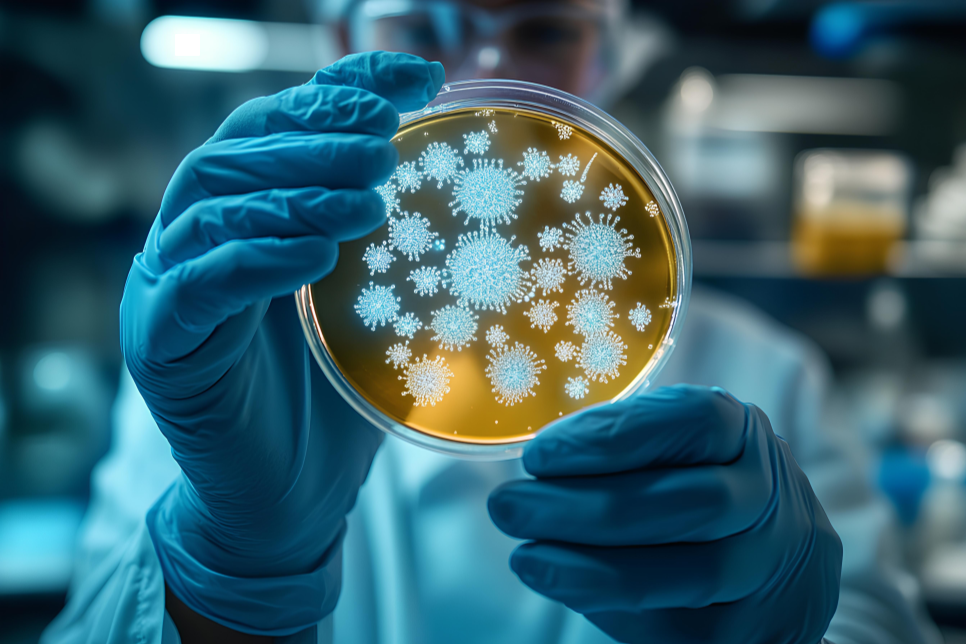

"장마철, 약통에 달라붙고 눅눅해진 영양제!" 약 보관법이 필요해~
- 웰빙
- 2025. 7. 9.

아침에
간단하게 식사를 하고
영양제를 먹으려 하니
약통에 모두 달라붙었다.
어라? 툭툭 쳐봐도
떨어지질 않네...
먹을 영양제가
한 두개가 아닌데!
장마는 아직
끝나지도 않았는데!
어떡하지?...
걱정되어
자세히 알아본, 약 보관법!
함께 살펴보고 알아두자~
"습기 OUT! 건강 OK!"
장마철, 습기가 만든 작은 위기~

"장마철에는 약도 눅눅해진다고?!"
장마철이면
옷장 곰팡이 걱정,
축축한 빨래도 고민~
정작,
약통과 영양제 병 속까지
습기가 스며든다는 사실은
자칫 놓치기 쉽다.

무심코 두었던
알약이 흐물거리고,
괜찮겠지... 한,
습기 먹은 영양제가
그 효과를 잃는다면?
작은 부주의가
나와 가족의 건강을
스스로 해치는 순간이 될 수 있다.
"효능도 떨어지지만,
심하면 곰팡이가 필 수도..."
약과 영양제, 보관이 중요할까~

"약은 냉장보관에 좋은 게 아니다?!"
많은 사람들은
약을 냉장고에 넣으면
신선할 거라고 생각한다.
바로 나...
하지만 모든 약이
냉장보관에 적합한 건 아니었다.
동네 약사님 왈~
실온보관이 기본인 약은
냉장 보관 시,
온도 변화에 따라
수분이 맺히고,
성분이 깨질 수 있다고.

섭취하는 순간부터
몸속 밸런스를 바꾸는 만큼,
원래의 성분이 유지되는 게
가장 중요하다.
습기가 많은 여름엔
약의 유효성분이 변질되기 쉽고,
영양제의 흡수율도 떨어지기 쉽고~
특히
어린이,
시니어,
만성질환자가 있는 집이라면
더욱 주의해야 한다.
"설명서가 답이고,
약은 눅눅해지기 전에~"
잘못된 보관, 흔한 실수들~

"보관이 잘못되면, 실수하기 쉬워?!"
비닐팩에 밀봉하면 좋다?
잘못된 정보도 돌아다닌다.
하지만 비닐팩은
내부에 결로가 생기기 쉬워서
오히려 습기를 더 머금는다.
그리고
개봉한 영양제를
여러 개 섞어두는 것도 위험하다.
성분이 서로 반응하거나,
제조일자가 뒤섞여,
언제까지 먹어야 할지
기준이 모호해진다.
실제로,
사고로 번진 약 보관은
습기 먹은 알약을 먹고
복통을 호소한 사례~
아이가 곰팡이 핀 약을 먹고
장염 걸린 사례 등~
"사소해 보여도, 작게 시작해서
크게 번질 수 있겠네"
올바른 약 보관법~

"가장 기본보관은 뭐다?!"
기본 보관은
‘습기와 직사광선 차단’이다.
일반적으로 약물은
상온(15~25℃) 또는 실온(1~30℃)에서 보관!
냉장 보관이 필요한 약물은
병원이나 약국에서 알려주니 꼭 확인!
★ 제습제 활용
실리카겔 등 습기제거제를 넣어, 약통 속 습기 잡기
★ 영양제 용기
다른 통에 옮기면, 습기와 오염 노출의 위험이 커지기 때문에 원래의 용기에 그대로 보관

★ 욕실 보관 금지
매일 샤워로 습도가 가장 높은 공간이니 피하기
★ 냉장보관
- 사용설명서부터 잘 보고, 모르면 약국 가서 물어보기
- 일부 안약, 인슐린, 성장호르몬 주사제 같이 온도와 습도에 민감한 약물은 필수적!
★ 상온 보관
- 소분된 시럽 (냉장보관이 필요한 시럽은 설명서 꼭 확인)
- 안약 (직사광선이 들지 않은 상온, 일부 냉장보관이 필요한 안약은 약국 문의)
- 좌약 (서늘한 상온, 물렁하면 냉장고에 잠깐 넣은 후 사용)
★ 여행 시 보관
- 냉장보관 시럽약은, 실온 약으로 재처방받기
- 단거리 여행은 아이스팩, 보냉 약파우치 등으로 이동하기
"귀찮아서, 잊어버릴까 봐,
요일 약통에 잔뜩 넣어두었는데"
보관에서 시작하는 웰빙 라이프~

"장마철에도 안전하게, 건강하게?!"
어떤 영양제를 먹느냐 만큼이나
어떻게 보관하느냐가 중요하다.
습기로부터
약과 영양제를 지키는 것은
곧 나를 돌보는 일이니까...
이번 장마철엔
큰 후회로 돌아오기 전에
보관습관을 다시 점검해 보고~
약통 열어 상태도 확인해 보고~
습기 먹은 애들 있으면
이참에 싹~ 정리하고
제습제를 넣어두자!
습기의 틈새를 닫는 순간,
웰빙은 시작된다.
"습기야 가라! 내 약은 소중하니까~"
오늘의 Well-being 한마디!

약 하나 챙기는 게
뭐 대수냐 했는데...
습기는
나도 모르게 내 몸을 위협한다.
장마철이라고
약도 기분 따라 축축 쳐지나~
매일 먹어야 하는
각종 약들과 영양제,
단순히 챙겨 먹는 것에서
끝나지 않겠다는!
오늘부터
꼼꼼하게 살펴보고
지혜롭게 실천해 본다~
"나를 위해... 약통 습기점검 시작!"
< 함께 보면 좋은 글 >
폐의약품, 먹다 남은 약!
메가팩토리, 창고형 약국!
FAQ~ 자주 묻는 질문은?
Q. 냉장고에 넣으면 안전한 약도 있을까?
A. 냉장보관은 약 종류에 따라 다르니, 설명서 확인이 먼저다.
Q. 장마철엔 냉장보관이 안전하지 않을까?
A. 냉장보관이 오히려 습기 결로를 유발해 약효가 떨어질 수 있다.
Q. 영양제를 다른 통에 옮겨 담아도 될까?
A. 제조사가 설계한 원래의 용기가 가장 안전하다.
Q. 약통을 열었더니 곰팡이가 피었다. 어떻게 하면 될까?
A. 무조건 폐기! 재사용하면 절대 안 된다.
Q. 영양제가 눅눅하게 습기를 먹었다. 먹으면 어떻게 될까?
A. 복통이나 설사 등, 부작용이 생길 수 있으니 섭취하지 않는다.
Q. 비닐팩에 밀봉하면 괜찮지 않을까?
A. 비닐팩 내부에 결로가 생겨 더 위험할 수 있으니 권장하지 않는다.
Q. 욕실에 보관하면 안 될까?
A. 욕실은 집에서 습도가 가장 높아 약이 쉽게 변질된다.
Q. 제습제는 어디에 넣으면 좋을까?
A. 약통 안에 실리카겔을 동봉하거나, 약장에 제습제를 두면 도움이 된다.
'웰빙' 카테고리의 다른 글
| "2025 삼복, 초복/중복/말복!" 인사말, 날짜, 보양식 건강웰빙~ (19) | 2025.07.20 |
|---|---|
| “다음 주, 다시 장마권?" 집중호우 대비하는 안전 웰빙~ (10) | 2025.07.13 |
| "웰빙 농촌의 숨은 매력, ‘농촌투어패스’로 떠나는 느린 여행~ (18) | 2025.07.08 |
| "쌀 씻은 물이 누렇네? 여름 장마철, 쌀 곰팡이 걱정!" 건강한 보관법으로 웰빙 지키기~ (13) | 2025.07.07 |
| "[추가지급 확정] 7월 21일부터!" 민생회복 소비쿠폰 총정리, '국민비서 알림서비스' 신청하자~ (20) | 2025.07.05 |